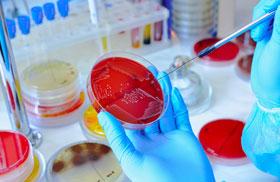

UPDATES
Be in the know with the latest news and updates
from ACTS Review Center

NEWS
Get to know the latest news and announcements concerning your stay with us at ACTS Review Center.
COMMUNITY
Check out the latest events at ACTS Review Center and get involved with members of the community.
TESTIMONIAL
Find out why ACTS Review Center is considered the best review center for medical technology in the Philippines.
TOPNOTCHERS
Be inspired by the stories behind the success of our board topnotchers and how we helped change their lives.
ACTS Review Center
Location:
Room 509 5th Floor J & T Building
3894 Ramon Magsaysay Boulevard Sta. Mesa, Manila Philippines 1016
Office Hours:
8:00 AM to 5:00 PM
Mondays to Saturdays, except holidays
Telephone:
Mobile:
